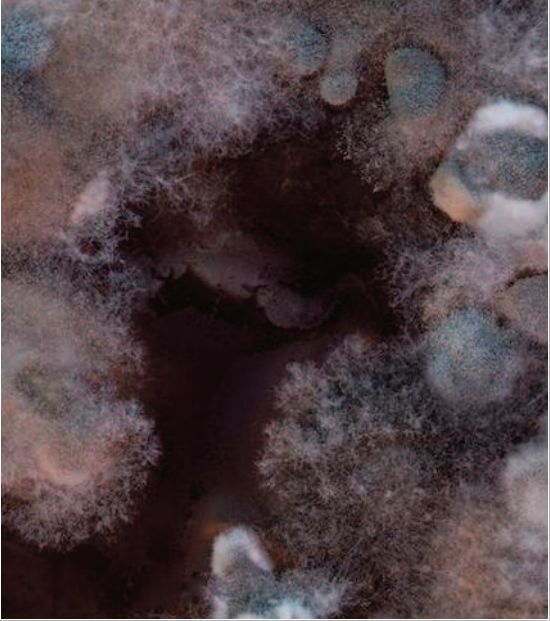
图片

【限量秒杀】Gallinee保湿身体乳200ml 益生菌益生元复合物配方(限量3瓶)
| 运费: | ¥ 0.00-20.00 |
| 库存: | 3 件 |
商品详情

1988年,Roth RR发表了一篇关于皮肤与微生物的论文,他说:“我们生活在充满微生物的环境中,但这些微生物中只有少数成为皮肤表面的居民。这些常驻微生物与皮肤构成了一个复杂的生态系统。”
今天,皮肤微生物被认知为皮肤屏障的一部分。改善皮肤微生态,成为干皮/敏皮/油痘皮们改善皮肤底子的新希望。

皮肤微生态研究的黄金时代
2003年4月15日,国际人类基因组组织宣布:投资10亿美金的人类基因组计划(HGP)全部完成。
微生物学家们发现,人类=10%人 + 90%微生物

肠道微生物学家Jeroen Raes名言:我们不是人类,而是一个行走的微生物群。
| 2008:皮肤常驻细菌获得“居住证”
美国国家卫生研究院(NIH)开始浩浩荡荡地开展人体微生物研究计划-(HMP)。皮肤微生态研究大牛Grice EA用16S rRNA测序(类似于人类的DNA测序)为皮肤上的微生物们做了身份鉴定,从此大家都是有居住证的菌了。
长期居住证 = 常驻微生物,构成皮肤微生态的关键
临时居住证 = 临时微生物,时不时来串门的活跃分子。
Grice同时也发现,在皮肤微生物的特征上,人和人的差距,比人和老鼠的差距还大。

| 2009:益生菌治痘专业认证
Grice EA发表了创时代意义的一组数据,记录了皮肤20个区域的菌群分布情况,眼花缭乱要搞大事,同一个人身上,没有两个部位的菌群是相同的。
同年,著名皮肤科医生Jean Krutmann也坐不住了,出来刷了下存在感,综述性总结了益生菌和益生元对护肤的应用: 调节痘痘肌,强化皮肤屏障,调节免疫力,提高抗紫外线(UVB)的能力,帮助皮炎皮肤恢复健康。
现在看来,Krutmann除了没有预见到后来益生菌在抗衰老的广泛应用,还是说的比较全面的。
| 2011:皮肤=菌群帮派的江湖
Grice EA 在2009数据的基础上,绘制了非常著名的人体皮肤菌群分布图。将上至前额,下至脚底板,粗至后背,细至鼻尖至翼褶,身体20个边边角角的皮肤菌群都做了细致的图谱展示。

这幅图现在的引用率爆表,妥妥是21世纪的达芬奇手稿的地位。
在文中,他又一次强调:皮肤上绝大多数的微生物都是无害,甚至是有益的。
换句话说:你浑身上上下下的每一个犄角旮旯,都是不同微生物帮派们的江湖。你,能好好活着不难受,是因为它们给面子,能在自己地盘上长治久安。

微生态护肤
进入小而美的应用发展期
| 2012:细菌护肤开创者-益生菌喷雾
这一年MIT校友会创立了AOBiome公司,将氨氧化细菌(AOB细菌)作为专利的Peacekeeper益生菌,用于炎症性疾病的治疗,包括皮肤上的痤疮,特异性皮炎,玫瑰痤疮,甚至于糖尿病病足等皮肤问题。

这项技术应用在了一个护肤品牌MotherDirt中,AO+益生菌系列除了含专利AOB混合体,还主打生物友好性与成分极简 -- 每个产品都只含十种以下成分。能为干皮/油皮/敏感皮改善皮肤底子,减少对其他护肤品以及底妆的依赖。技术优秀,背景过硬,去年差点儿上市。
| 2013: 论文写出个品牌-微生态护手霜
法国药剂学家Marie Drago发表过一篇关于微生物与皮肤的正经论文,算是这个小领域内的专家。受够了15年的打工生涯后,这一年她开始筹备一个自主品牌Gallinee,并在两年后成功发布。 特色是三位一体,将益生菌+益生元+后生元,同时应用到了一个配方中。

Galinee第一个打响的产品是La Culture护手霜,La culture在法语里是“文化”的意思,也可以理解为“培养基”,我们的手就是一个细菌培养基。
| 2015:活菌封印术
Esse是一个研究皮肤益生菌的研究机构。2015年,他们推出了号称全球第一个“每毫升封印了一百万个益生菌”的精华液。当接触皮肤时,封印的益生菌被皮肤中的水分激活,和皮肤本身的菌群融合,从此愉快地生活在一起。主打功效是抗衰老。

全球性关注微生态护肤
国际大牌纷纷上车
| 2016:皮肤微生态论文发表增加到3万篇
Microbiome Heritage (微生物遗传)一词引发讨论,父辈们遗传给我们的不止是DNA, 还有全身的微生物组成。在一项宏基因组学研究中发现,微生物对我们非常的忠诚,不仅对特定的皮肤部位表现出强烈的栖息偏好性,而且形成了个人独特的微生物印迹(microbial fingerprint)。
到底是我决定了我的微生物,还是微生物造就了我?这是从此之后的新思考。
Gallinee益生菌身体乳(参考价:130元)

秋冬容易起皮的肌肤其实需要调养好,不然只能一直依赖身体乳,Gallinee的益生菌身体乳乍一听就觉得很神奇。富含益生菌益生元成分,是能够保护肌肤屏障的,所以在滋润保湿的同时能够慢慢调理我们的肌肤。尤其乳酸能够软化角质,抚平干燥,干皮真的很需要了。

虽然保湿力好,但是在质地上它偏清透,乳液虽不流动但是很好抹开。不只能够保湿肌肤,还能调节肌肤PH值,所以还有光滑肌肤缓解鸡皮的效果。香味是淡淡的益生菌加果木的香味,不会刺鼻很好闻。




商品名称:【清仓好价】Gallinee保湿身体乳200ml 益生菌益生元复合物配方

- 一家卖冠军单品的折扣店 (微信公众号认证)
- 扫描二维码,访问我们的微信店铺
- 随时随地的购物、客服咨询、查询订单和物流...














